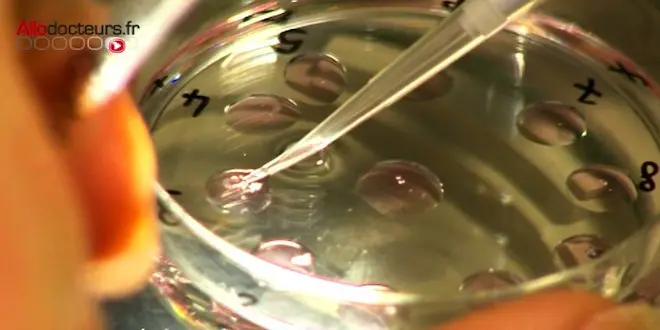

PMA : pas de destruction des actuels stocks de gamètes
La révision de la loi de bioéthique pourrait permettre de lever l'anonymat des donneurs de gamètes. Les stocks de gamètes déjà constitués continueraient à être utilisés en cas de passage à ce nouveau mode de don.
Par La rédaction d'Allo Docteurs
Mis à jour le
C’est une évolution de la loi qui était réclamée de longue date par les associations : la levée de l'anonymat pour les donneurs de gamètes.
Pour tous les dons effectués après l'entrée en vigueur de la nouvelle loi de bioéthique, si elle est votée, les enfants conçus par PMA pourraient connaître l'identité du donneur sur demande dès leur majorité. Pour les dons précédant la loi, l'accord du donneur resterait obligatoire. Mais la ministre de la Santé a jugé nécessaire, lundi 26 août, la mise en place d'une période de transition avant le passage au nouveau système de dons pour éviter une pénurie.
Pas de destruction totale du stock de gamètes
"On ne détruira pas complètement le stock de gamètes", a annoncé ce lundi la ministre sur France Inter. "Le stock de gamètes va continuer à être utilisé en attendant que nous constituions un autre stock de gamètes qui répondra aux nouvelles exigences, c’est-à-dire que le donneur ait donné son consentement à pouvoir être recontacté par le jeune à l'âge de 18 ans".
Le projet de loi bioéthique, qui inclut l'ouverture de la PMA à toutes les femmes, sera examiné à l'Assemblée nationale en septembre. La commission spéciale installée en vue de l'examen du texte doit entamer ses auditions lundi 26 août.
Accord indispensable du donneur
Le projet de loi prévoit que les enfants nés d'un don après l'entrée en vigueur de la loi puissent accéder à leur majorité à des "données non identifiantes" (âge, caractéristiques physiques, etc.) du donneur et à son identité. Pour cela, l'accord du donneur est nécessaire.
Conséquence : désormais, pour donner son sperme, un homme devra obligatoirement accepter que son identité puisse un jour être révélée à l'enfant né de ce don, si ce dernier le souhaite. Si cet homme ne l'accepte pas, il ne pourra pas donner.
Un don qui reste anonyme
Le don lui-même restera anonyme : on ne pourra toujours pas choisir son donneur et un donneur ne pourra pas choisir à qui il donne.
Selon le ministère de la Santé, il y a environ 150.000 tentatives de PMA par an, avec tiers donneur ou non (la plupart des couples hétérosexuels font des PMA avec leurs propres gamètes).
Ces tentatives donnent lieu à 25.000 naissances chaque année (sur un total de 800.000), parmi lesquelles environ un millier est issu d'un tiers donneur.
"Il y aura par décret une date pivot à laquelle nous déciderons de changer de système", a expliqué la ministre précisant qu'avant cette date, il n'y aura pas de levée d'anonymat.










